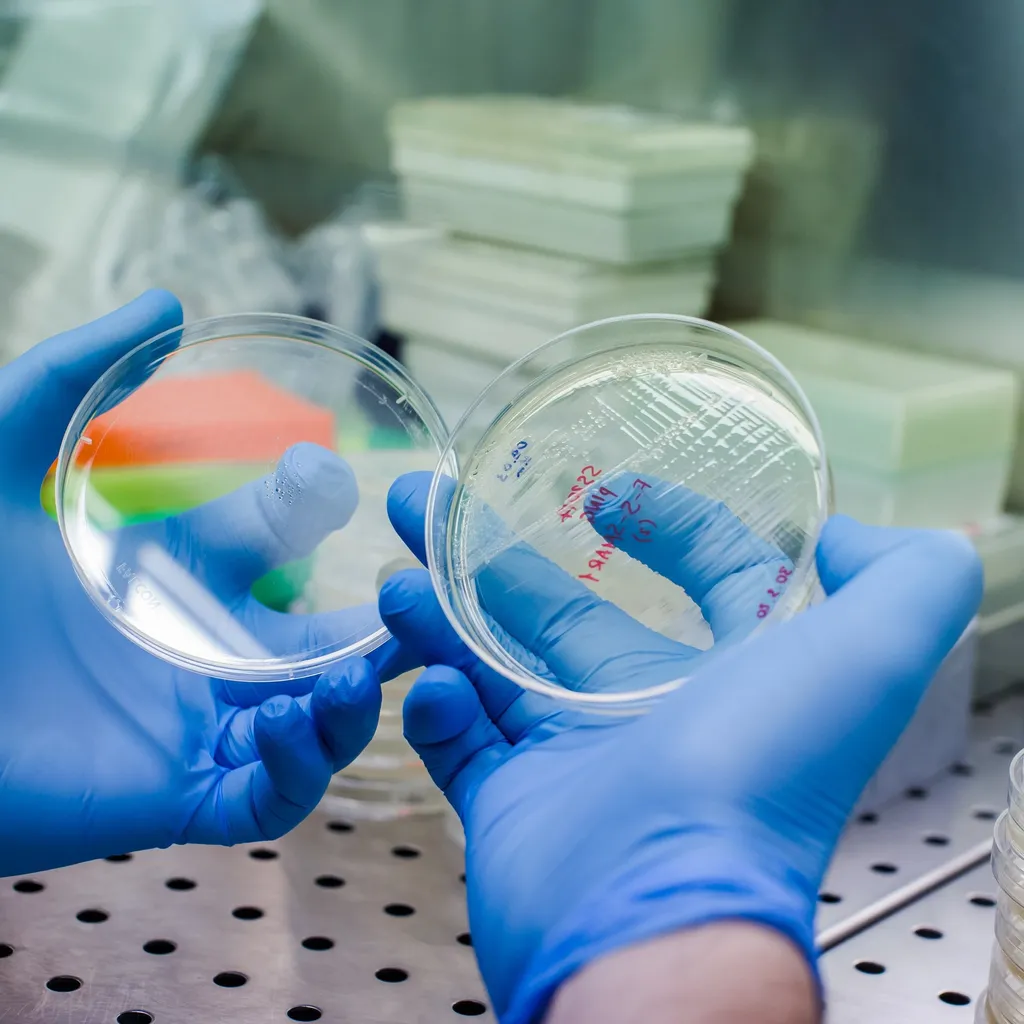

A 2023 Update on CAR-T Therapy in Myeloma with Dr. Craig Hofmeister
Event Description
Dr. Craig Hofmeister, multiple myeloma specialist from Emory, presents an update on the role of CAR-T therapy in multiple myeloma. What products are currently FDA approved and what new products have been developed? Will the product become more widely available? Will it ever become front-line therapy? The answers to these questions and more will be discussed in this important meeting.
Schedule & Agenda

Audrey introduces the agenda of the event and featured speaker Stephanie Wiese.

Audrey introduces the agenda of the event and featured speaker Stephanie Wiese.

Dr. Craig Hofmeister presents an update on the role of CAR-T therapy in multiple myeloma.

Dr. Craig Hofmeister presents an update on the role of CAR-T therapy in multiple myeloma.
Type your questions in the chat and we will answer them!
Type your questions in the chat and we will answer them!
Speakers & Moderators

Audrey joined the HealthTree Foundation as the Myeloma Community Program Director in 2020. While not knowing much about myeloma at the start, she has since worked hard to educate herself, empathize and learn from others' experiences. She loves this job. Audrey is passionate about serving others, loves learning, and enjoys a nice mug of hot chocolate no matter the weather.

Craig C. Hofmeister, MD, MPH, is Professor in the Department of Hematology and Medical Oncology at Emory University School of Medicine. Board certified in internal medicine and hematology, Dr. Hofmeister’s practice focuses on plasma cell cancers, including plasmacytomas, multiple myeloma, AL amyloidosis, smoldering myeloma, and monoclonal gammopathies of renal significance. He started practicing with Emory Healthcare in 2018.
Join the Conversation
This event is part of the Treatments & Drugs group in HealthTree Connect, a social media platform for people with blood cancer. If you want to connect with other patients and caregivers and talk about this topic, join HealthTree Connect.
Have Any Questions?
Thank you for your interest in the event. If you have any questions, we would love to help!
Feel free to give us a call or send us a message below.
Get In Touch With Us
1-800-709-1113
Support@healthtree.org





Get the Latest Multiple Myeloma Updates, Delivered to You.
By subscribing to the HealthTree newsletter, you'll receive the latest research, treatment updates, and expert insights to help you navigate your health.